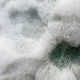
The Nivara Sage Drift Ripple Straw 3D Wall Art by Giant Sculptures features clustered white straws arranged vertically, creating a textured pattern with circular openings—ideal for adding depth and modern flair to your decor.

Nivara Sage Drift Ripple Straw 3D Wall Art
Choose options
Other Customers Also Bought
You Might Also Like

Inspiring
Captivating Designs
Explore a diverse collection of wall art styles, from modern minimalism to bold statement pieces, each designed to spark imagination and enhance your living or working space.

Unique
Handcrafted Art
Each art piece is meticulously handcrafted to order by our skilled artisans, ensuring every creation is one of a kind. Combining traditional techniques with innovative design, every detail is carefully perfected to deliver a stunning centerpiece that exudes luxury and individuality.

Unmatched
premium Materials
We use only the finest materials and paints, the same quality finishes found in luxury automotive and design industries, ensuring a stunning result that will last for years to come.

Tailored
Fully Bespoke
From colour finishes and sizes to materials and design features, we can fully customize each piece to complement your space. Choose from optional LED lighting, frames, or create a bespoke design to suit your vision.

Illuminating
LED Lighting
Enhance your art with integrated LED lighting options. Expertly crafted to enhance each piece, the lighting adds depth, drama, and a sophisticated glow, transforming your art into an unforgettable statement, day or night.

Complimentary
Worldwide Shipping
We offer seamless worldwide delivery. Each piece is expertly packaged for maximum protection and shipped fully insured, ensuring your art arrives safely at your door.
Experiences Shared
Our Reviews
@Giant.sculptures
Join our 45k+ followers on social media to explore striking stainless steel designs, perfect for contemporary luxury interiors.














































































































